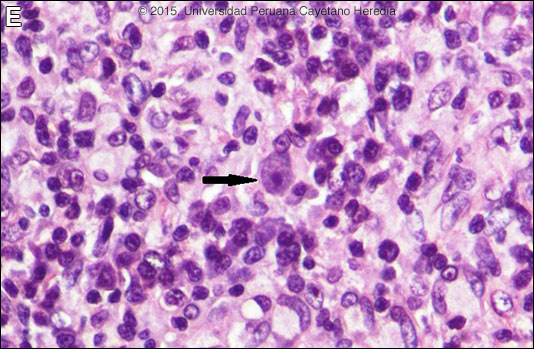

|
Gorgas Case 2015-06 |
 |
|
The following patient was seen on the inpatient ward of the Children’s Hospital in Lima, Perú.

 History: 3-year-old male patient admitted with a 3-month history of a painless, progressive, macular and violaceous lesion on the nose that occurred 3-months after a fall in front of his house. The patient was first referred to the Peruvian Cancer Institute before we saw him. Previously healthy child fully vaccinated for his age. No visual problems.
Epidemiology: Born and lives in the district of Mórrope, department of Lambayeque in the coastal desert of Perú, in a house made of adobe, with no running water or sewage. Drinks well water. Contact with cats, dogs, pigs and chickens. No history of fresh-water exposure in lakes, ponds or rivers. No known TB contact. No relevant family history, no similar illnesses in the community. Physical Examination: Percentile weight for height: (50-75); percentile weight for age: (25-50). Afebrile, pulse 128, respirations 28. An infiltrative red-violaceous lesion was observed on the nose that extended to the right chin and affected the inner angle of the upper and lower right eyelids, with thickening of the right nasal mucosa and marked obstruction of the lumen [Image A]. Deviation of the globe, but ophthalmology and neurology consultants found normal ocular movements, normal visual acuity, and normal retinal and vitreous examinations. No lymphadenopathy. No oral or mucosal lesions. The rest of the exam was normal. Laboratory Examination: Hematocrit: 31%, hemoglobin: 9.5 g/dL, platelets: 315,000. WBC 6,900 (normal differential, no eosinophils); normal liver function tests. CT scan of the nasal sinuses revealed an extensive process in the right maxillary sinus extending to the ethmoidal and right orbital areas, compatible with lymphoma or rhabdomyosarcoma. MRI disclosed an infiltrative process of the soft tissues surrounding the nose but extending to the nasal septum, maxillary and ethmoidal sinuses, and right orbital area, infiltrating the medial and inferior rectal muscles and brain parenchyma [Images B, C, D]. 
 |
|
Diagnosis: Balamuthia mandrillaris (free-living amoeba).
Discussion: Skin biopsy revealed an inflammatory response, mainly composed of lymphocytes and plasma cells, with poorly formed granulomas with multinucleated giant cells. No evidence of cancer was seen. A trophozoite of a free-living amoeba with a small eccentrically located nucleus and vacuolated cytoplasm is shown [Image E, arrow]. As other species of free-living ameba are not known to occur in Perú, and other species do not begin with a typical cutaneous lesion, a diagnosis of Balamuthia mandrillaris was made. See Gorgas Cases 2007-10 and 2004-02 for other patients with cutaneous manifestations of this infection. About 200 cases of B. mandrillaris infection have been reported from all continents except from Africa. Most cases are reported in the western hemisphere, with the highest concentration in South America and the United States. The disease appears to occur more frequently among patients of Hispanic origin; possible explanations include genetic susceptibility or environmental exposure. We have seen over 60 cases at our institution and, like most Latin American cases, the patient is not immunocompromised. Unlike Acanthamoeba and Naegleria species, which are more familiar to clinicians and known to occur in brackish ponds and creeks, an ecologic niche in nature has not been definitively found for Balamuthia. Our patients have come from throughout Perú, and often have a history of swimming in potentially contaminated fresh water or a history of trauma and contamination of wounds with soil. Entry of water into the nasal mucosa and the olfactory nerve endings is thought to occur with Acanthamoeba and Naegleria. Naegleria infection causes an acute necrotizing and suppurative meningoencephalitis, an aggressive disease that is generally fatal in days. Acanthamoeba cause a sub-acute granulomatis encephalitis with a more prolonged but ultimately fatal course. Occasionally patients with Acanthamoeba have a skin lesion usually described as a chronic ulcer. Acanthamoeba, unlike Balamuthia, has been associated also with amoebic keratitis, a painful sight-threatening disease of the eye. In Balamuthia infection the disease may follow a prolonged course, but most frequently has a fatal outcome. Almost all cases have an initial skin lesion, and this lesion precedes the inevitable CNS disease (granulomatous amebic encephalitis) by weeks or months. The CNS lesions generally appear distant or as metastases from the primary cutaneous lesion but uncommonly, as in this case, there may be direct local extension to the brain. Patients have ranged from 3 to 65 years of age with 50% under age 15. The typical skin lesion is a single painless plaque up to several centimeters in diameter; a few patients have had 2 to 3 lesions. Color may be skin tone, dark red, or slightly violaceous. Sensation is preserved. Location is usually on the central face with fewer than 10% with initial lesions on trunk or extremities. For facial lesions the differential diagnosis may include tuberculosis, mucocutaneous leishmaniasis, leprosy, sporotrichosis, paracoccidioidomycosis, and rhinoscleroma. Mucormycosis usually has a faster and more aggressive course. Sarcoid, discoid lupus, and Wegener’s can also be considered. Histologically, granulomatous inflammation with lymphocytes, histiocytes, plasma cells, as well as giant cells, is characteristic. Amoebic trophozoites are often scanty and multiple sections need to be examined. Some foci of vasculitis may be present. CNS involvement most often manifests with headache, photophobia, seizures that progress to lethargy, sensorimotor deficit, coma and death. The CNS lesion is a progressive hemorrhagic necrosis with large numbers of amoebic trophozoites and cysts invading vascular sub-adventitial areas of arteries, veins, and capillaries, leading to perivasculitis and cerebral infarcts [Hum Pathol. 1999 Mar;30(3):269-73]. The mainstay of successful treatment depends on early diagnosis and therapy. Patients without brain lesion at diagnosis have better chances of recovery. Treatment with drug combinations for prolonged periods is warranted. This patient was started on fluconazole, albendazole, and miltefosine. In our experience with B. mandrillaris, 5 out of 9 patients (56%) treated with this combination healed completely [Clin Infect Dis. 2010;51(2):e7-11]. Two of those patients had brain lesions at diagnosis and recovered without sequelae. This drug regimen is well tolerated; the most important side effects are nausea, stomachache, and vomiting. The duration of treatment in most of these cases was from 6 to 18 months. Miltefosine is known to have an in-vitro amebicidal effect against B. mandrillaris [J Eukaryot Microbiol. 2006 Mar-Apr;53(2):121-6] and crosses the blood-brain barrier. Although formal trials are lacking, a number of case reports have shown good results when using miltefosine as part of a combination of drugs to treat free-living affections, including Naegleria sp., Acanthamoeba and B. mandrillaris, and in the United States miltefosine is available from the CDC for treatment of free-living amoebas. Albendazole and fluconazole are amebistatic effect; they interfere on the metabolism of ergosterol, one of the main components of the ameba wall. Fluconazole has good CNS penetration.. Other drugs with amebicidal effect are pentamidine and the antipsychiatric agents phenothiazine and thioridazine, however, they are badly tolerated. Other successful combinations include pentamidine or miltefosine plus: sulfadiazine, flucytosine, clarithromycin and thioridazine or trifluoperazine. Recent in vitro studies show loperamide, haloperidol, apomorphine, procyclidine, and amiodarone as promising drugs. No therapy has been shown to be highly effective in curing Balamuthia infection. With IV amphotericin B or pentamidine, an initial and apparently favorable response or disappearance of cutaneous lesions still does not halt the eventual appearance of CNS disease. Similarly, in our hands, multi-drug combination therapy with agents such as albendazole, itraconazole, or fluconazole without miltefosine have still resulted in eventual appearance or progression of CNS disease. Acknowledgement: We thank Dr. Jorge Candela, treating physician from the Children's Hospital, and Drs. Francisco Bravo and Dalila Martínez from the Tropical Medicine Institute.
|